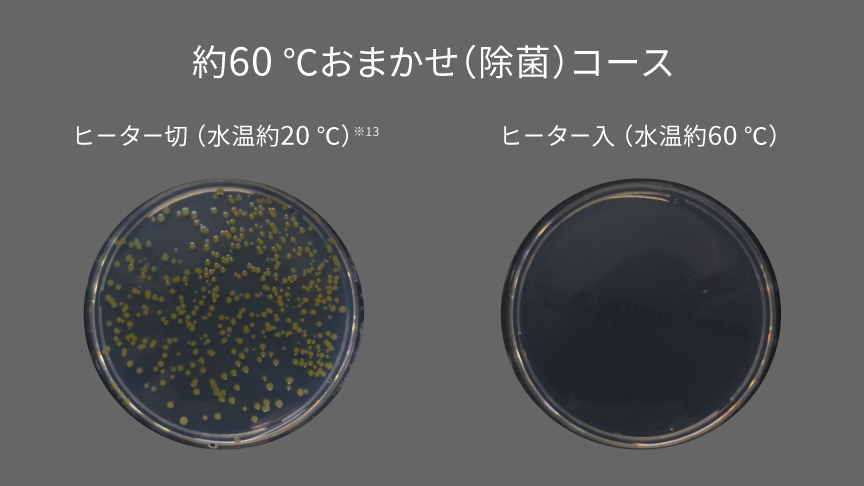
約60℃おまかせ（除菌）コース｜ヒーター切（水温約20℃）・ヒーター入（水温約60℃）の比較イメージ

SDシリーズ特長:温水スゴ落ち泡洗浄


温水の力で、黄ばみやニオイ※1、
菌※2までスゴ落ち
- 〈消臭の試験内容〉[試験機関]近江オドエアーサービス(株)[試験方法]部屋干し臭が付着したタオルハンカチを6段階臭気強度表示法にて評価[消臭方法]高濃度洗剤液と加熱温水洗浄による[対象部分]ドラム内の衣類 [試験結果]「おまかせ」: 3.3、「約40 ℃においスッキリ」: 1.7
- 〈除菌の試験内容〉[試験機関](株)エフシージー総合研究所 [試験方法]菌液付着試験布の生菌数測定 [除菌方法]約60 ℃おまかせ(除菌)コースにて。加熱高温水による[対象部分]ドラム内の衣類[試験結果]菌の減少率99 %以上(自社換算値)
| 対応機種 |
|---|
| SD10HB |
「お湯」の温度をキープして洗う
温水スゴ落ち泡洗浄のしくみ
センサーで水温を検知。洗濯槽下にある温水専用ヒーターのON/OFFを制御して設定温度を保ちます。

洗剤中の酵素が活性化する温度まで洗剤液を温め、さらに泡にすることで浸透力もアップ。
繊維の奥にしみついた、黄ばみや部屋干し臭のニオイ※1の元まで洗い落とします。
さまざまな洗浄コースでしつこい汚れもスッキリ。
おしゃれ着や毛布にも対応


- 〈消臭の試験内容〉[試験機関]近江オドエアーサービス(株)[試験方法]部屋干し臭が付着したタオルハンカチを6段階臭気強度表示法にて評価[消臭方法]高濃度洗剤液と加熱温水洗浄による[対象部分]ドラム内の衣類 [試験結果]「おまかせ」: 3.3、「約40 ℃においスッキリ」: 1.7
- 〈除菌の試験内容〉[試験機関](株)エフシージー総合研究所 [試験方法]菌液付着試験布の生菌数測定 [除菌方法]約60 ℃おまかせ(除菌)コースにて。加熱高温水による[対象部分]ドラム内の衣類[試験結果]菌の減少率99 %以上(自社換算値)
- 電力料金目安単価31円/kWh(税込)[家電公取協調べ。2022年7月改定]で計算。
コースの使い分け方
1. 気になる菌・ニオイ対策に
2. 黄ばんでしまった衣類に
5. 季節の変わり目のお手入れに
白物衣類の除菌※2に
約60 ℃おまかせ(除菌)コース
| 対応機種 |
|---|
| SD10HB |
高温の温水で、白物衣類をしっかり除菌※2。
(容量:2 kgまで)
白物衣類だけを洗ってください。
衣類の素材・量、衣類の汚れ、洗剤の種類、水質、水温、室温などによって効果は異なります。
普段着の黄ばみ除去に
約40 ℃つけおき(普段着)コース
| 対応機種 |
|---|
| SD10HB |

あきらめていた普段着の黄ばみを約3時間で落とす
(容量:2 kgまで)
約40 ℃に温めた高濃度洗剤液※14に衣類を浸しながら洗浄。普段着の黄ばみを約3時間でしっかり除去します。
この写真の黄ばみは、着用時の皮脂汚れによるものです(シャツ 綿100 %)。
写真は約40 ℃つけおき(普段着)コース(洗濯)設定時(運転時間約177分)粉末合成洗剤を通常の約2倍使用、洗濯容量2 ㎏運転の場合の洗浄実験結果です(当社調べ)。
日光などで変色した汚れ・黄ばみは落ちません。
衣類の素材・量、衣類の汚れ、洗剤の種類、水質、水温、室温などによって効果は異なります。
約40 ℃つけおき(普段着)コース行程
(運転時間 約177分)


約40 ℃つけおきコースを上手にお使いいただくために
衣類の取扱い絵表示を確認してください。
- 水温の上限がある衣類は、上限を超えて洗わないでください。
- 手洗い指定や水洗いできない衣類は、洗わないでください。
衣類を傷めたり、色移りしたりすることがあるため、絵表示を確認し、色落ちするものは分け洗いをしてください。
生乾きのイヤなニオイに
約40 ℃においスッキリコース
| 対応機種 |
|---|
| SD10HB |

部屋干し臭のニオイの元を洗い落とす※1
(容量:2 kgまで)
洗剤中の酵素が活性化する約40 ℃の温水で2回洗い※14、繊維の奥までしっかり洗浄。部屋干しなどによる生乾きのイヤなニオイの発生を抑えるので、清潔感あふれる仕上がりを実感できます。色柄物もOKです。
使用環境・状況によって効果は異なります。
約40 ℃においスッキリコース行程
(洗濯運転時間 約93分)


普段着の皮脂汚れ予防に
約40 ℃おまかせコース
| 対応機種 |
|---|
| SD10HB |
皮脂の蓄積を防ぐ(容量:4.5 kgまで)
黄ばみの主な原因は、普段の洗濯で落としきれずに蓄積した皮脂汚れです。定期的な温水洗浄で、皮脂の蓄積を防ぎます。
使用環境・状況によって効果は異なります。
水温が低い日に
約15 ℃洗濯モード(自動)
| 対応機種 |
|---|
| SD10HB |

寒い日は自動で水を温めて、洗浄力アップ
水温が低いとき(15 ℃以下)は、自動で水温を上げて洗濯。寒い冬の朝や夜でも洗浄力を発揮します。
- 約15 ℃洗濯モード(自動)はお買い上げ時オフ設定です。設定時は所要時間が最大20分長くなります。
- 写真は、洗濯3 kg時おまかせコースにおいて。当社実験による(くつ下 綿、アクリル、ナイロン、ポリウレタン) 。
- 衣類の素材・量、衣類の汚れ、洗剤の種類、水質、水温、室温などによって効果は異なります。
デリケートなおしゃれ着のお手入れに
約30 ℃おしゃれ着コース
| 対応機種 |
|---|
| SD10HB |

汚れたおしゃれ着をやさしく洗える
(洗濯容量:2 kgまで)
デリケートなおしゃれ着も、約30 ℃に温めた洗剤液でやさしく洗います。

- 写真は、弱水流推奨衣類2 kg、粉末合成洗剤を使用し各コースそれぞれ20回ずつ運転した場合。当社実験による。
約30 ℃おしゃれ着コースは洗濯のみのコースです。
衣類の素材・量、衣類の汚れ、洗剤の種類、水質、水温、室温などによって効果は異なります。
おしゃれ着の黄ばみ予防に
約40 ℃おしゃれ着コース
| 対応機種 |
|---|
| SD10HB |

おしゃれ着の黄ばみ予防に
(洗濯容量:2 kgまで)
大切なおしゃれ着を、変色やニオイから守ります。白物のおしゃれ着洗いにもおすすめです。
- 約40 ℃おしゃれ着コースは洗濯のみのコースです。
おしゃれ着の黄ばみ除去に
約40 ℃つけおき(おしゃれ着)コース
| 対応機種 |
|---|
| SD10HB |

あきらめていたおしゃれ着の黄ばみも、温水でスッキリ
(洗濯容量:2 kgまで)
黄ばんでしまったおしゃれ着も、約7時間(洗い行程は約6時間)かけてやさしくつけおき洗い※14。さらに、脱水時も衣類が傷みにくいように、槽の回転数を工夫しています。
この写真の黄ばみは、着用時の皮脂汚れによるものです(本体:レーヨン 75 % / ナイロン 25 %、レース部分:ポリエステル 100 %)。
写真は約40 ℃つけおき(おしゃれ着)コース(洗濯)設定時(運転時間約415分)粉末合成洗剤を通常の約2倍使用、洗濯容量2 ㎏運転の場合の洗浄実験結果です(当社調べ)。
日光などで変色した汚れ・黄ばみは落ちません。
約40 ℃つけおき(おしゃれ着)コースは洗濯のみのコースです。
衣類の素材・量、衣類の汚れ、洗剤の種類、水質、水温、室温などによって効果は異なります。

約40 ℃つけおき(おしゃれ着)コース行程
(運転時間 約415分)


おしゃれ着コースのポイント
パナソニックはデリケートなおしゃれ着も温水でケア

おしゃれ着洗剤の他、通常の洗剤も使えます※15。
※洗剤のパッケージデザインは変更になる可能性があります
約30 ℃おしゃれ着コース・約40 ℃おしゃれ着コース
衣類が傷みにくいように、約1/3の機械力で洗い、脱水時間を短く、槽の回転数も工夫しています。
いずれも当社おまかせコースとの比較。おまかせ:脱水時間約6分→おしゃれ着:脱水時間約3分。
約40 ℃つけおき(おしゃれ着)コース
脱水時間を短くし、回転数を抑えておしゃれ着をやさしくケアします。
約40 ℃つけおき(普段着)コースとの比較。普段着:脱水時間約6分→おしゃれ着:脱水時間約3分。
蓄積した皮脂汚れに
約40 ℃毛布コース
| 対応機種 |
|---|
| SD10HB |
毛布の蓄積した皮脂汚れをスッキリ洗浄 (洗濯容量:4.2 ㎏まで/乾燥容量:3 ㎏まで)



こまめに洗うのは難しい毛布のしつこい皮脂汚れは、約40 ℃の約1.5倍洗剤液でしっかりと落とします。汗をかきやすい夏場の敷きパッドのお手入れにもおすすめです。
その他おすすめ特長
いまの私にちょうどいい。
コンパクトドラム SDシリーズ
- 製品の色は、ご使用のスマートフォン、ディスプレイ、タブレットの種類や設定により、実際の色と若干異なります。また、見る角度・照明・床や周囲の色調などにより、色のイメージは掲載写真とは見え方が異なります。
- 各コースの衣類写真の黄ばみ・汚れは、着用時の皮脂・食べこぼし・泥汚れによるものです。衣類の素材・量、衣類の汚れ・洗剤の種類、水質、水温、室温などによって効果は異なります。
- 室温・水温、水道水圧、設置・排水条件、衣類の量や種類、衣類の片寄りなどにより、使用水量・消費電力量・運転時間が増減します。
衣類の量、水温などにより設定の温度まで上がらないことがあります。
- 〈消臭の試験内容 〉[試験機関] 近江オドエアーサービス(株)[試験方法] 部屋干し臭が付着したタオルハンカチを6段階臭気強度表示法にて評価 [消臭方法] 高濃度洗剤液と加熱温水洗浄による [対象部分] ドラム内の衣類 [試験結果] 「おまかせ」:3.3、「約40 ℃ においスッキリ」:1.7。
- 〈除菌の試験内容〉[試験機関](株)エフシージー総合研究所 [試験方法]菌液付着試験布の生菌数測定 [除菌方法]加熱高温水による [対象部分]ドラム内の衣類 [試験結果]菌の減少率99 %以上(自社換算値)。
- 電力料金目安単価31円/kWh(税込)[家電公取協調べ。2022年7月改定]で計算。1回あたりの電気代(洗濯~脱水)はあくまで目安であり、水温、衣類の量によって異なります。
- 2 ㎏洗濯時、約60 ℃おまかせ(除菌)コース(洗濯)設定時、水温を20 ℃から60 ℃に上げる場合。
- 2 ㎏洗濯時、約40 ℃つけおき(普段着)コース(洗濯)設定時、水温を20 ℃ から40 ℃に上げてつけおき洗いする場合。
- 4.2 ㎏洗濯時、約40 ℃毛布コース(洗濯)設定時、水温を20 ℃から40 ℃に上げる場合。
- 2 ㎏洗濯時、約40 ℃においスッキリコース(洗濯)設定時、水温を20 ℃から40 ℃に上げる場合。
- 2 ㎏洗濯時、約40 ℃つけおき(おしゃれ着)コース(洗濯)設定時、水温を20 ℃から40 ℃に上げてつけおき洗いする場合。
- 4.5 ㎏洗濯時、約40 ℃おまかせコース(洗濯)設定時、水温を20 ℃から40 ℃に上げる場合。
- 2 ㎏洗濯時、約40 ℃おしゃれ着コース(洗濯)設定時、水温を20 ℃から40 ℃に上げる場合。
- 2 ㎏洗濯時、約30 ℃おしゃれ着コース(洗濯)設定時、水温を20 ℃から30 ℃に上げる場合。
- 定格10 ㎏洗濯時、おまかせコース(洗濯)・約15 ℃洗濯モード設定時、水温5 ℃から15 ℃に上げる場合(水温、衣類の量によって異なります)。
- 約60 ℃おまかせ(除菌)コースはヒーター切(水温約20 ℃)で運転できません。
- おまかせコースと比べ、洗剤約2倍量の高濃度洗剤液で洗います。
- 衣類の絵表示に従って洗剤をお使いください。








